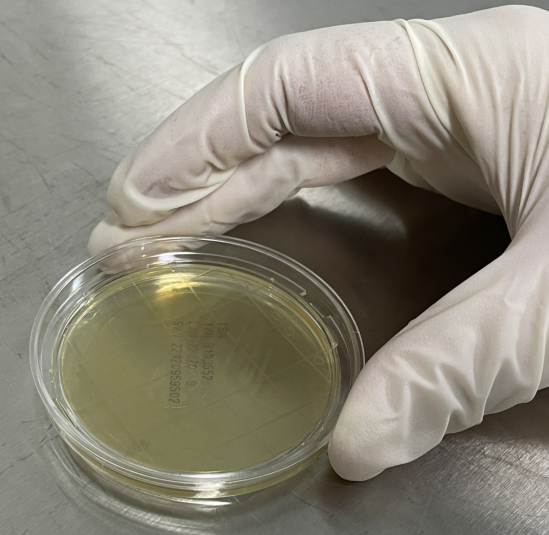

2022年11月18日,市場監(jiān)管總局修訂發(fā)布《嬰幼兒配方乳粉生產(chǎn)許可審查細(xì)則(2022版)》(以下簡稱《細(xì)則(2022版)》)�。《細(xì)則(2022版)》自發(fā)布之日起實(shí)施��。原食品藥品監(jiān)管總局2013年12月16日發(fā)布的《嬰幼兒配方乳粉生產(chǎn)許可審查細(xì)則(2013版)》同時(shí)廢止�����。
《細(xì)則(2022版)》在清潔作業(yè)區(qū)表面微生物控制方面進(jìn)行了修訂——刪除采樣參考標(biāo)準(zhǔn)(GB 15982)�����、增加兩種采樣方法(接觸碟法�、擦拭法)。

嬰幼兒配方乳粉生產(chǎn)許可審查細(xì)則(2013版)

嬰幼兒配方乳粉生產(chǎn)許可審查細(xì)則(2022版)
那么��,接觸碟法和擦拭法采樣具體應(yīng)該怎么操作呢����?這里我們結(jié)合以下兩個(gè)標(biāo)準(zhǔn),分別介紹兩種采樣方法供大家參考��。
?
參考標(biāo)準(zhǔn):
GB 15982-2012 醫(yī)院消毒衛(wèi)生標(biāo)準(zhǔn) 附錄A(擦拭法)
SN/T4426-2016 出口食品加工衛(wèi)生表面取樣技術(shù)方法(接觸碟法�、擦拭法)
1.?擦拭法



1) 在表面涂抹采樣管上標(biāo)記樣品信息。
2) 將5cm×5cm滅菌規(guī)格板放置于待采樣物體表面,在規(guī)格板內(nèi)橫豎往返各涂抹5次���,并隨之轉(zhuǎn)動(dòng)棉拭子�。
3) 將采樣后的拭子放回采樣管中��,旋好蓋子����,充分震蕩混勻,使拭子采集到的樣品充分釋放����。



4) 吸取1mL采樣液添加于平板中。(必要時(shí)可參考GB4789.2-2022進(jìn)行10倍梯度稀釋����。)
5) 傾注適宜培養(yǎng)基,搖勻����,待凝固后在適宜溫度培養(yǎng)�����。
6) 培養(yǎng)后進(jìn)行菌落計(jì)數(shù)。
注:
門把手等小型物體則采用棉拭子直接涂抹物體采樣����;
若采樣物體表面有消毒劑殘留時(shí),采樣液應(yīng)含相應(yīng)中和劑�。
2.?接觸碟法

1) 拆開包裝,取出接觸皿��。

2) 將帶有瓊脂的一面穩(wěn)固的按壓于待測試表面��,避免發(fā)生位移��。(在接觸時(shí)間10s���,壓力相當(dāng)于500g的情況下效果最佳�。)
3)將接觸碟于36℃±1℃培養(yǎng)48h±2h,計(jì)數(shù)每皿(55mm)的菌落數(shù)�。
優(yōu)品推薦
